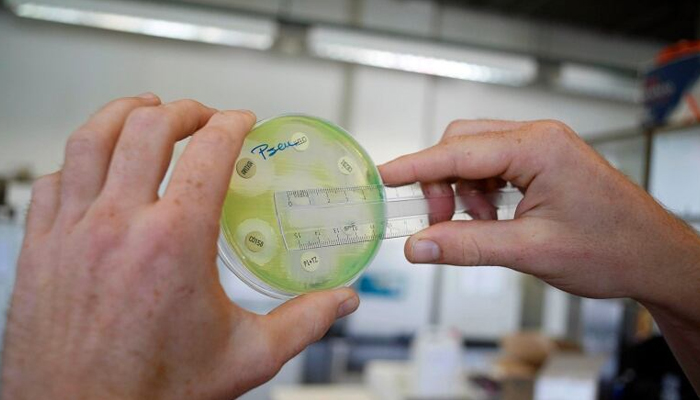

Hurricane in Florida moves on, but may leaves deadly disease behind to worry about
Officials in Florida began warning residents of potential for flesh-eating bacterial infections as soon as state of emergency was declared
After the powerful hurricane unravelled its full might upon Florida, the threat gradually vanished however, it has left an invisible menace behind for the people in the state, Vibrio vulnificus — a type of flesh-eating bacteria.
Florida Health Department press secretary Jae Williams said: "The rare and potentially deadly type of flesh-eating bacterium should not be taken lightly. It needs to be treated with proper respect — the same way we respect alligators and rattlesnakes."
According to Williams, health officials in the state began warning residents of the potential for such bacterial infections as soon as the state of emergency was declared.
Areas with leftover water due to storms and coastal areas are at risk.
"The rainwater, being freshwater, dilutes the seawater and brings the salinity down," said James Oliver, a retired professor of microbiology at the University of North Carolina, Charlotte, creating perfect conditions for the bacteria.
According to the CDC, this infection affects an estimated 80,000 people in the US annually, claiming about 100 lives.
The warning comes citing previous hurricane seasons as after the storm last time, Ian stormed through, 38 were infected in which three people had to have at least one leg amputated, and 11 died.
A similar thing happened after Hurricane Katrina in 2005.
Flesh-eating bacteria infection
Necrotizing fasciitis or flesh-eating disease, can occur due to a number of bacteria including group A strep and other bacteria found in water, dirt or saliva. This condition seriously threatens life.
Bacteria enter through a wound and start killing tissue under the skin that surrounds the muscles, nerves, fat and blood vessels. As it spreads quickly infection takes place within hours or a few days.
"Speed is essential. These are the fastest-growing bacteria known to man," Oliver said.
It is necessary to contain infection by amputations but in some cases, infected ones die within a day.
"Just realize that you're eating a live animal and you're eating the intestinal contents of whatever it ate, which typically is Vibrio," Oliver said.
As it thrives in warmer waters, Alabama, Florida, Georgia, Louisiana and Mississippi are among the states at risk.
"The chances of getting it are increasing because it's spreading geographically and in larger numbers because of the warmer waters," Oliver said.
There were three cases of death related to this infection in New York.
"It is virtually guaranteed that if you wade into coastal waters this weekend, you will encounter such bacteria," Oliver said.
"While that is a scary statement, it is important to understand that the risk of becoming sick from that encounter is extremely low for the vast majority of people."
Dr Rachael Lee, an associate professor in the division of infectious diseases at the University of Alabama at Birmingham suggested: "If you've got any sort of wound on your leg or develop a wound while you're at the beach, you really want to try to protect yourself and not expose yourself to water in those cases. If you don't have wounds, then the risk of wading in the water is practically zero.
-
Shocking discovery at 'no-kill' shelter leaves dog owners distraught
-
EU launches investigation into Sanofi over alleged flu vaccine disparagement
-
How to survive Heatwave: Expert tips to stay cool in extreme temperatures
-
Rare genetic clue linked to healthy aging found in long-lived families
-
French fries raise diabetes risk 20%: New study warns
-
Study shows near-zero cervical cancer risk in young women
-
HPV vaccine study finds sharp fall in cervical cancer mortality
-
FDA upgrades Alfredo sauce recall affecting 41 states to ‘highest risk’ level